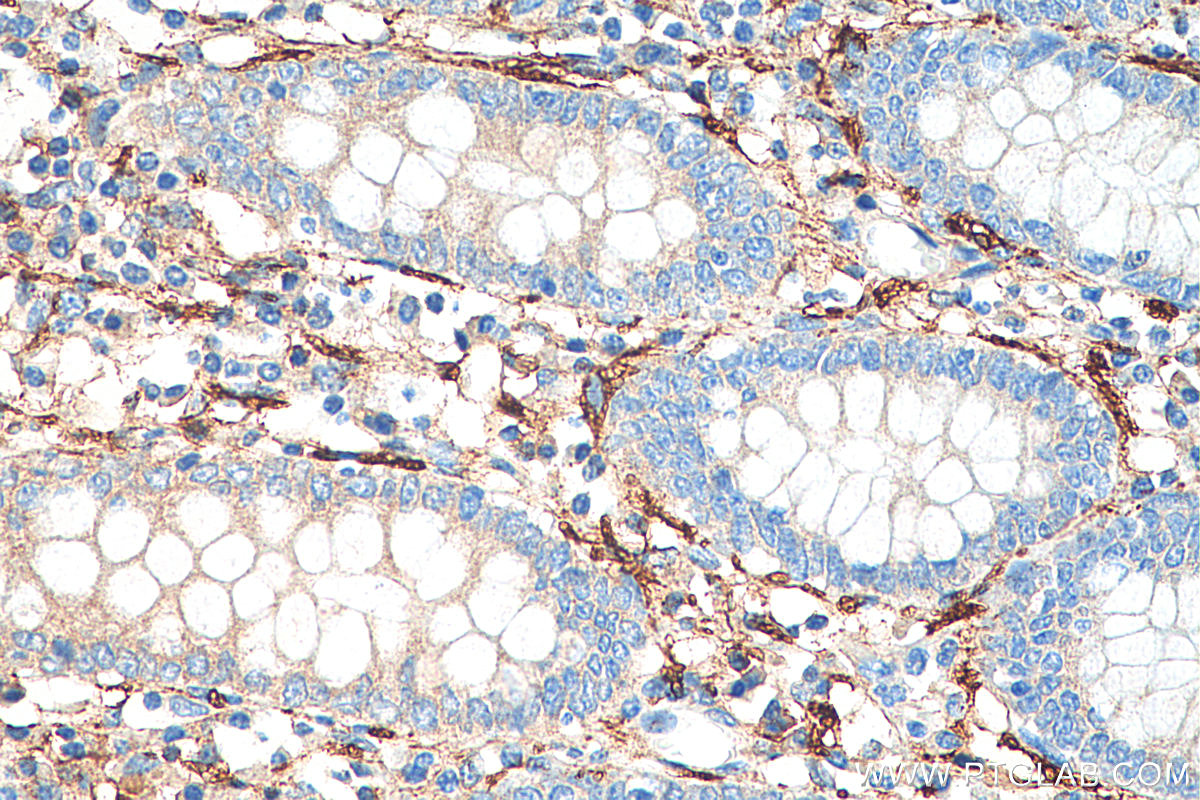

验证数据展示
经过测试的应用
| Positive WB detected in | mouse brain tissue, Neuro-2a cells, rat brain tissue, pig brain tissue |
| Positive IHC detected in | human tonsillitis tissue, human appendicitis tissue, human colon tissue, human lung cancer tissue, Insulinoma tissue, mouse brain tissue, mouse colon tissue, rat brain tissue Note: suggested antigen retrieval with TE buffer pH 9.0; (*) Alternatively, antigen retrieval may be performed with citrate buffer pH 6.0 |
| Positive IF-P detected in | mouse colon tissue |
| Positive IF/ICC detected in | SH-SY5Y cells |
推荐稀释比
| 应用 | 推荐稀释比 |
|---|---|
| Western Blot (WB) | WB : 1:5000-1:50000 |
| Immunohistochemistry (IHC) | IHC : 1:8000-1:32000 |
| Immunofluorescence (IF)-P | IF-P : 1:50-1:500 |
| Immunofluorescence (IF)/ICC | IF/ICC : 1:50-1:500 |
| It is recommended that this reagent should be titrated in each testing system to obtain optimal results. | |
| Sample-dependent, Check data in validation data gallery. | |
产品信息
14255-1-AP targets NCAM1/CD56 in WB, IHC, IF/ICC, IF-P, ELISA applications and shows reactivity with human, mouse, rat, pig samples.
| 经测试应用 | WB, IHC, IF/ICC, IF-P, ELISA Application Description |
| 文献引用应用 | WB, IHC, IF |
| 经测试反应性 | human, mouse, rat, pig |
| 文献引用反应性 | human, mouse, rat, pig |
| 免疫原 |
CatNo: Ag5528 Product name: Recombinant human NCAM1/CD56 protein Source: e coli.-derived, PGEX-4T Tag: GST Domain: 30-352 aa of BC047244 Sequence: EISVGESKFFLCQVAGDAKDKDISWFSPNGEKLTPNQQRISVVWNDDSSSTLTIYNANIDDAGIYKCVVTGEDGSESEATVNVKIFQKLMFKNAPTPQEFREGEDAVIVCDVVSSLPPTIIWKHKGRDVILKKDVRFIVLSNNYLQIRGIKKTDEGTYRCEGRILARGEINFKDIQVIVNVPPTIQARQNIVNATANLGQSVTLVCDAEGFPEPTMSWTKDGEQIEQEEDDEKYIFSDDSSQLTIKKVDKNDEAEYICIAENKAGEQDATIHLKVFAKPKITYVENQTAMELEEQVTLTCEASGDPIPSITWRTSTRNISSEE 种属同源性预测 |
| 宿主/亚型 | Rabbit / IgG |
| 抗体类别 | Polyclonal |
| 产品类型 | Antibody |
| 全称 | neural cell adhesion molecule 1 |
| 别名 | CD56, NCAM1, MSK39, N CAM 1, NCAM |
| 计算分子量 | 95 kDa |
| 观测分子量 | 120 kDa, 140 kDa, 180 kDa |
| GenBank蛋白编号 | BC047244 |
| 基因名称 | NCAM1 |
| Gene ID (NCBI) | 4684 |
| ENSEMBL Gene ID | ENSG00000149294 |
| RRID | AB_2149421 |
| 偶联类型 | Unconjugated |
| 形式 | Liquid |
| 纯化方式 | Antigen affinity purification |
| UNIPROT ID | P13591 |
| 储存缓冲液 | PBS with 0.02% sodium azide and 50% glycerol, pH 7.3. |
| 储存条件 | Store at -20°C. Stable for one year after shipment. Aliquoting is unnecessary for -20oC storage. |
背景介绍
Neural cell adhesion molecule 1 (NCAM1, also known as CD56) is a cell adhesion glycoprotein of the immunoglobulin (Ig) superfamily. It is a multifunction protein involved in synaptic plasticity, neurodevelopment, and neurogenesis. NCAM1 is expressed on human neurons, glial cells, skeletal muscle cells, NK cells and a subset of T cells, and the expression is observed in a wide variety of human tumors, including myeloma, myeloid leukemia, neuroendocrine tumors, Wilms' tumor, neuroblastoma, and NK/T cell lymphomas. Three major isoforms of NCAM1, with molecular masses of 120, 140, and 180 kDa, are generated by alternative splicing of mRNA (PMID: 9696812). The glycosylphosphatidylinositol (GPI)-anchored NCAM120 and the transmembrane NCAM140 and NCAM180 consist of five Ig-like domains and two fibronection-type III repeats (FNIII). All three forms can be posttranslationally modified by addition of polysialic acid (PSA) (PMID: 14976519). Several other isofroms have also been described (PMID: 1856291).
实验方案
| Product Specific Protocols | |
|---|---|
| IF protocol for NCAM1/CD56 antibody 14255-1-AP | Download protocol |
| IHC protocol for NCAM1/CD56 antibody 14255-1-AP | Download protocol |
| WB protocol for NCAM1/CD56 antibody 14255-1-AP | Download protocol |
| Standard Protocols | |
|---|---|
| Click here to view our Standard Protocols |
发表文章
| Species | Application | Title |
|---|---|---|
Nat Med Selective modulation of the androgen receptor AF2 domain rescues degeneration in spinal bulbar muscular atrophy. | ||
Nat Immunol Short IL-18 generated by caspase-3 cleavage mobilizes NK cells to suppress tumor growth | ||
Cell Metab Multiplexed In Situ Imaging Mass Cytometry Analysis of the Human Endocrine Pancreas and Immune System in Type 1 Diabetes. | ||
Sci Adv Gene therapy with AR isoform 2 rescues spinal and bulbar muscular atrophy phenotype by modulating AR transcriptional activity. | ||
J Clin Invest Thioredoxin activity confers resistance against oxidative stress in tumor-infiltrating NK cells. |